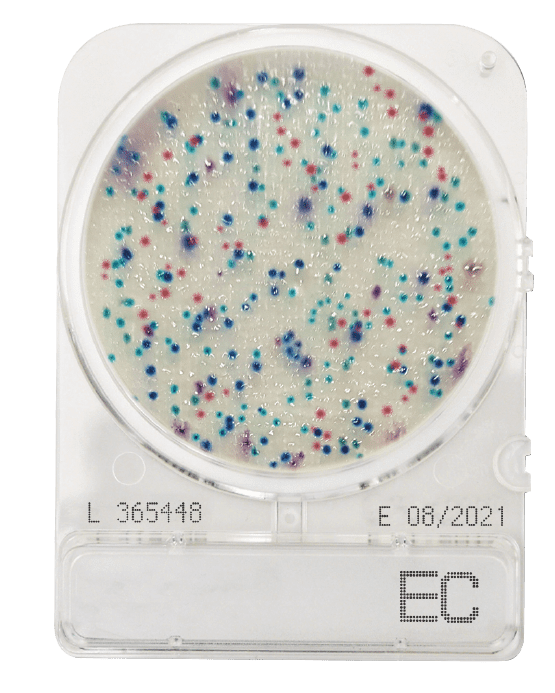
Placeholder image

Easy-to-use, dehydrated chromogenic culture media for Microbial Testing on Food, beverage and environmental surfaces
Compact Dry products are ready-to-use, dehydrated chromogenic media plates, that offer structural rigidity for safe handling and stacking. The sealed lid allows 3-dimentional growth and minimizes the risk of cross-contamination and spillage. This effective structural design, paired with dehydrated culture media removes the requirement for spreaders, unlike traditional plates and film media. Moreover, chromogenic additives for selective growth and colouration of colonies, make for rapid and efficient species identification and enumeration. The following Compact Dry plates are currently available form South Island Scientific:
- Compact Dry TC for Total Count
- Compact Dray EC for E.coli & Coliforms
- Compact Dry YM for Yeast & Mould
There is a large range of Compact dry options available, if you are looking for something other than the current stocked range – please don’t hesitate to make a request for these directly from our friendly team.
Product specifications:
Store at room temperature between +1°C to 30°C prior to use and protect from light exposure. Suitable for use with a range of Matrices:
- Raw Materials - food product and ingredients
- Processed Food Stuffs - food, drinks, ready meals
- Environmental Surfaces - test your surfaces using buffered swabs and Compact Dry
Incubation times:
Compact Dry TC
- Incubate at 35 ± 2 °C for 48 ± 3 hours with AOAC | NordVal and MicroVal at 30 ± 1 °C for 48 ± 3 hours
Compact Dry EC
- Incubate at 35 ± 2 °C for 24 ± 2 hours with AOAC | NordVal and MicroVal at 37 ± 1 °C for 24 ± 2 hours
Compact Dry YM
- Incubate at 25 ± 1 °C for 3 – 7 days with AOAC, NordVal and MicroVal
Result Interpretation:
Compact Dry TC – All colonies Red
Compact Dry EC – E.coli colonies are Blue / Blue-purple, while coliforms colonies are red. Total number of coliforms is all red + blue / blue-purple colonies.
Compact Dry YM – Yeast colonies are blue to white to cream coloured, shiny textured colonies, while mould colonies are green to black to white coloured, cottony/ fuzzy colonies
Incubation, Result interpretation & Disposal after use:
Please refer to individual kit Directions for use, Result interpretation & Disposal after use information for correct procedures.
